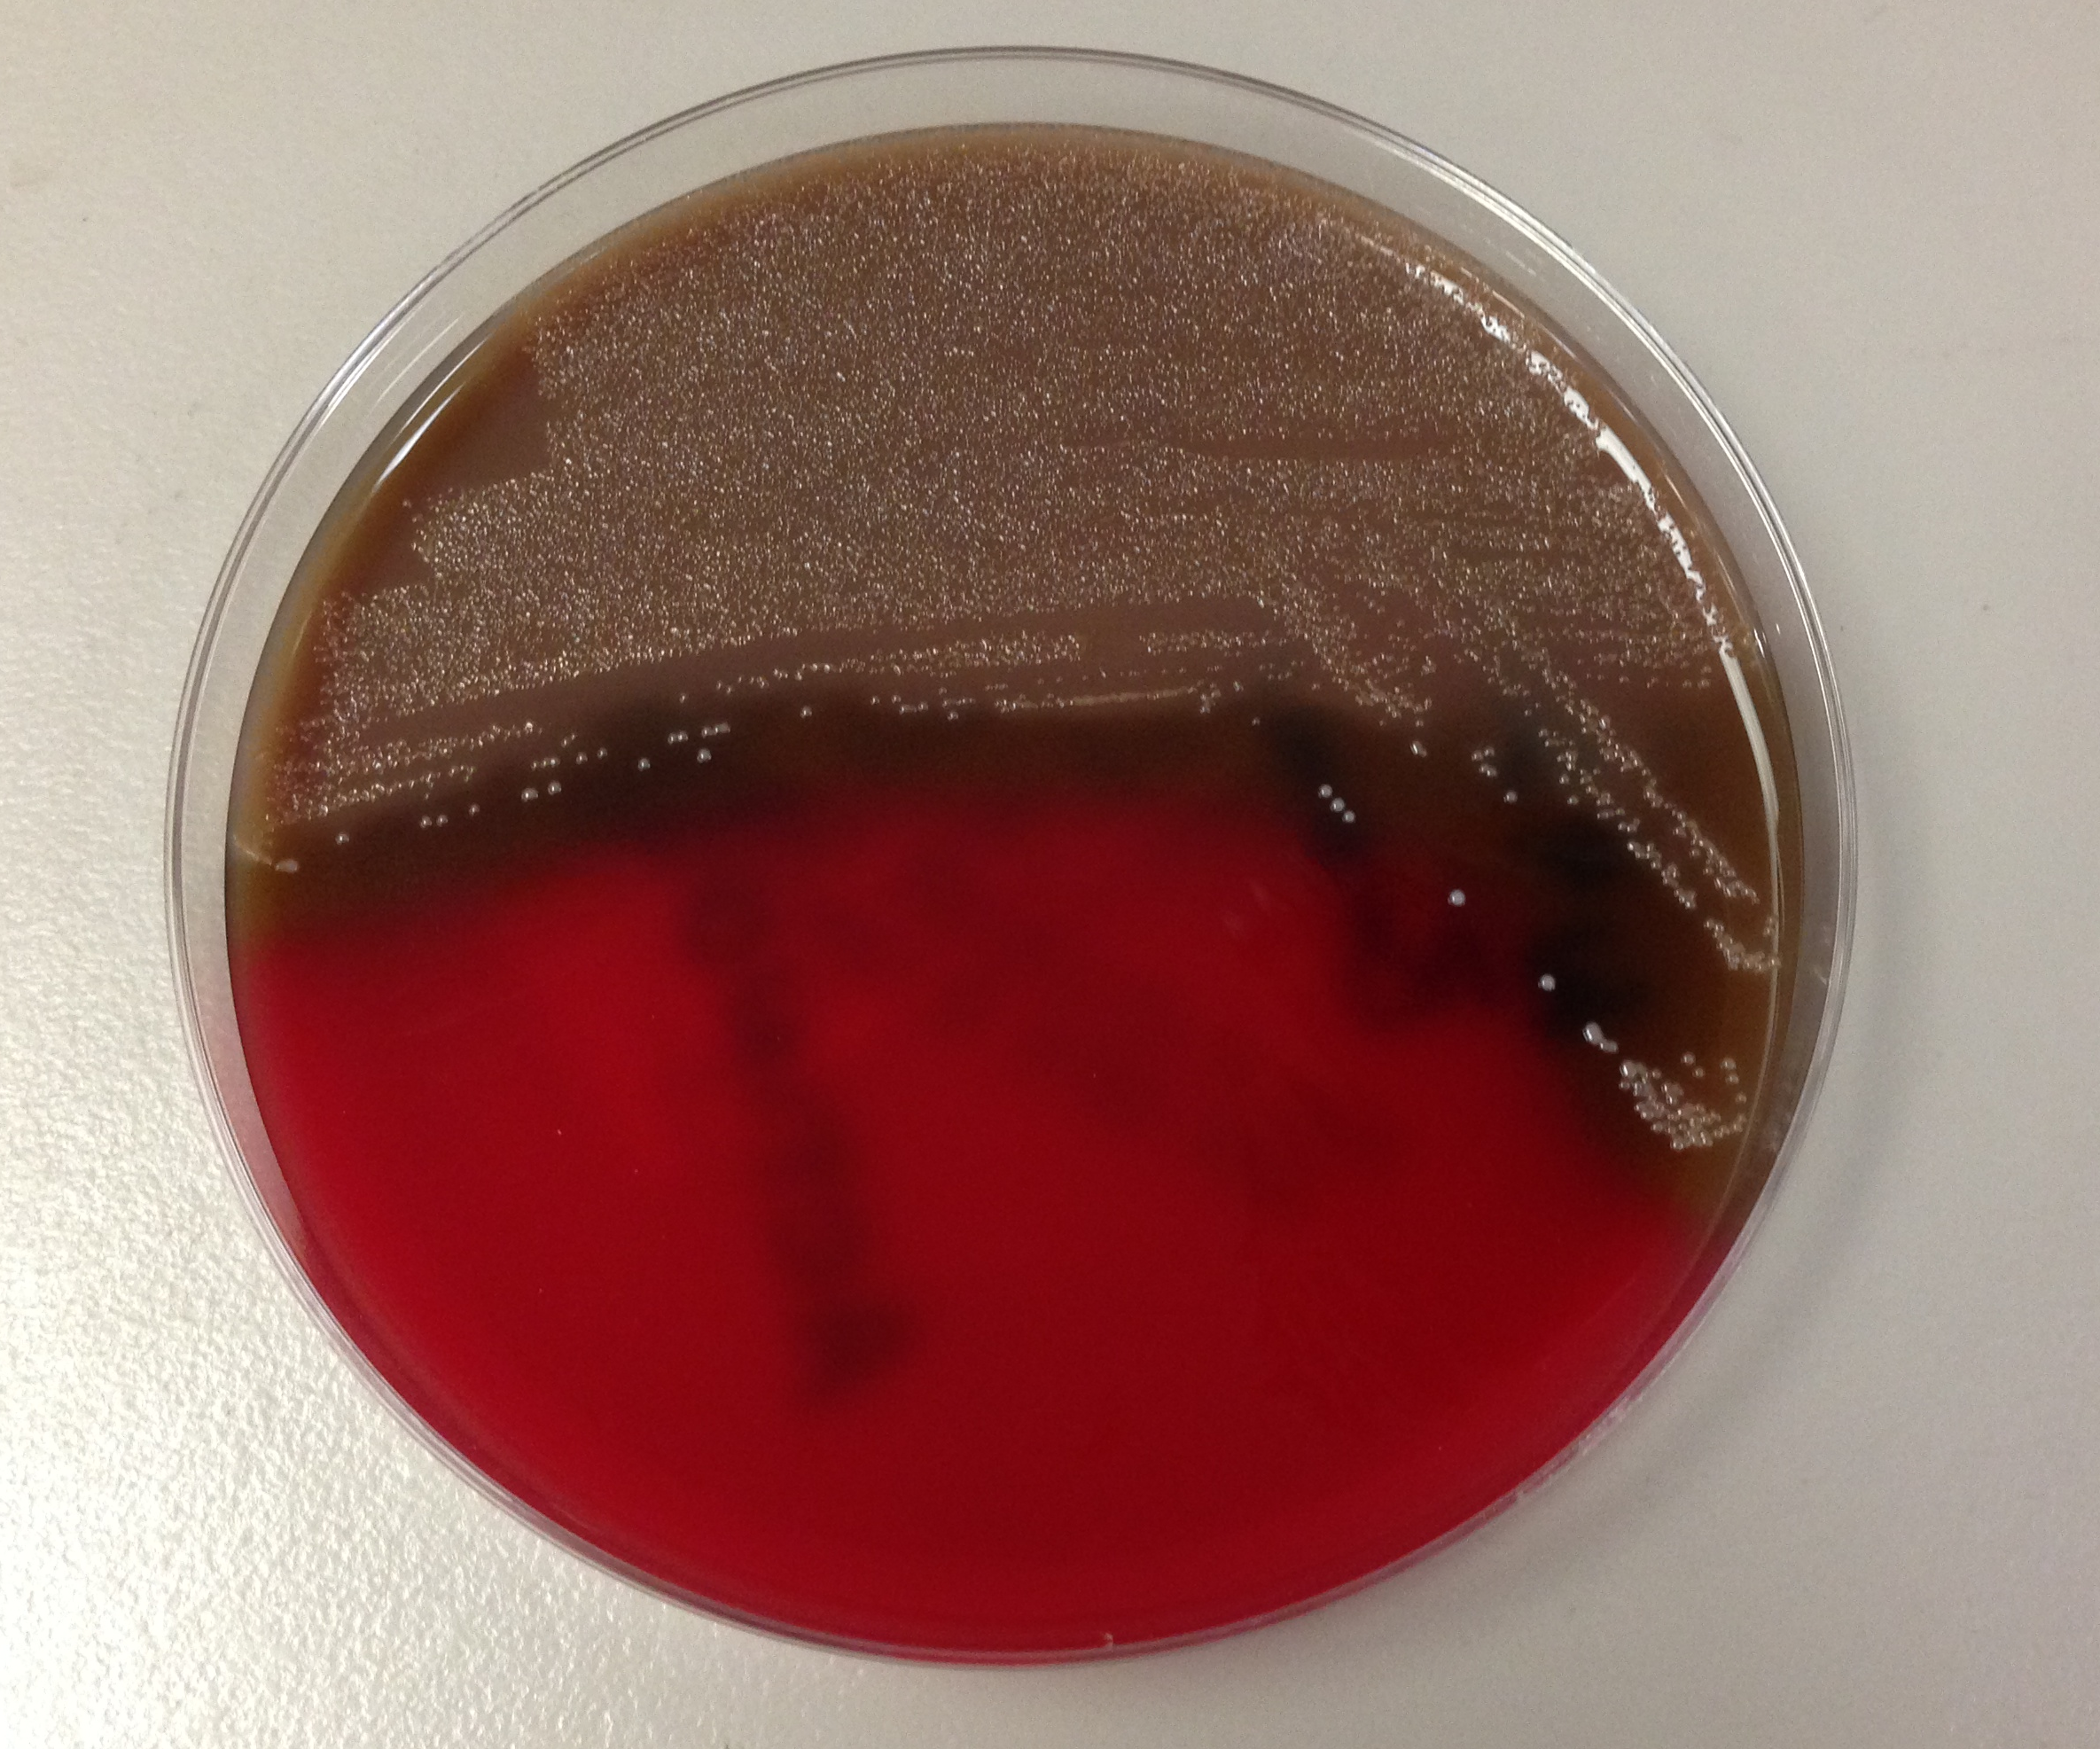

A 68 year old woman with a past medical history of type 2 diabetes mellitus presented with a foot wound clinically consistent with a diabetic foot ulcer. Imaging of the patient’s foot demonstrated a large abscess of the plantar aspect of her foot with extension to the surrounding soft tissues. The patient was taken to the operating room and incision and drainage was performed. Fluid from the wound was submitted to the microbiology laboratory and was planted aerobically and anaerobically. Growth was observed on the anaerobic blood plate with the below gram stain and colony morphology:

Laboratory Identification:
The fluid received from the patient’s wound was cultured on aerobic and anaerobic grow plates. The bacteria only grew on anaerobic plates. Additionally, the gram stain revealed pleomorphic gram positive bacilli. These findings were suggestive of Actinomyces. Actinomyces species was confirmed by mass spectrometry.
Discussion:
Actinomyces are anaerobic gram positive bacteria that are normal flora of the oral cavity and throat. Actinomyces have variable gram stain and colony morphology. Our case, as shown above, demonstrates the pleomorphic nature of Actinomyces and does not exhibit the classic textbook morphology. The typical gram stain morphology of Actinomyces is branching, filamentous, beaded bacilli. This morphology overlaps with Nocardia. Actinomyces can be distinguished from Norcardia based on its anaerobic growth pattern and lack of partial acid fast staining (Nocardia are strict aerobes that stain partially acid fast). The bacterial colonies of Actinomyces are non-hemolytic, non-pigmented and are classically described as white and nodular (molar tooth shaped). Actinomyces forms “sulfur granules” in patient specimens which are hard yellow granules composed of bacterial filaments solidified with exudative material.
Actinomyces has the potential to cause opportunistic infections when transferred from an endogenous site to a sterile site of the body. Actinomyces is involved in a spectrum of human disease including actinomycosis, wound infections, abscesses, oral infections, genital tract infections, and urinary tract infections. Of these diseases, actinomycosis is the most infamous and is characterized by abscess formation, draining sinus tracts with sulfur granules, and tissue fibrosis. Actinomycosis is most commonly cervicofacial, but may also be thoracic, abdominal, pelvic or involve the central nervous system.
Treatment of Actinomyces includes surgical debridement if indicated and prolonged antibiotics for 3-6 months depending on antibiotic sensitivity. Antibiotic sensitivity ranges from penicillin, amoxicillin, tetracycline, erythromycin, and clindamycin.
Jill Miller, MD is a 2nd year anatomic and clinical pathology resident at the University of Vermont Medical Center.
-Christi Wojewoda, MD, is the Director of Clinical Microbiology at the University of Vermont Medical Center and an Assistant Professor at the University of Vermont.
